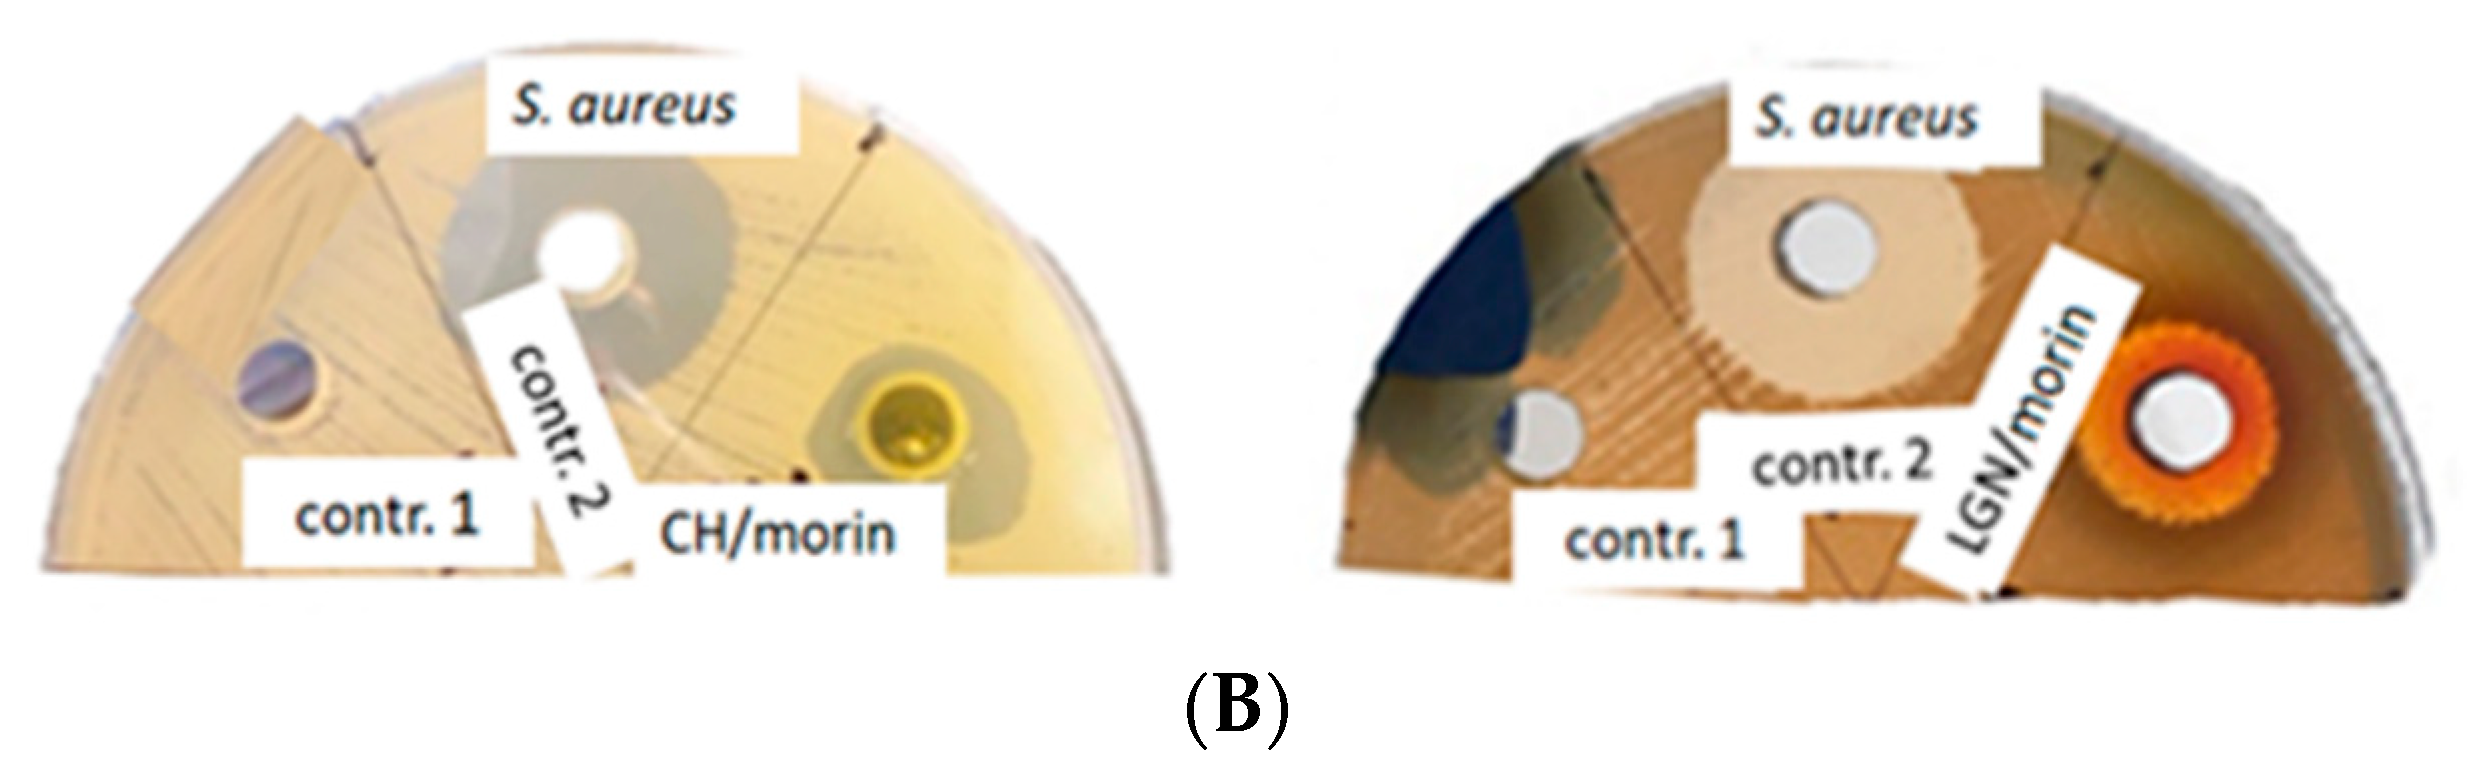
Antibiotics 11 00650 g002b 550

Antimicrobial Potential of Conjugated Lignin/Morin/Chitosan Combinations as a Function of System Complexity
Abstract
:1. Introduction
2. Results and Discussion
2.1. Comparative Analyses of the Antimicrobial Potential of Single-, Two- and Three-Component Lignin–Morin–Chitosan Systems
2.2. Structure–Activity Relationships: Effects of Flavonoid–Biopolymer, Biopolymer–Biopolymer and Flavonoid–Biopolymer–Bacteria Interactions on the Antimicrobial Activities of the Studied Conjugated Combinations
3. Materials and Methods
3.1. Chemicals
3.2. Flavonoid–Chitosan–Lignin Systems
3.3. Antimicrobial Screening
3.4. Statistical Analysis
4. Conclusions
Author Contributions
Funding
Informed Consent Statement
Data Availability Statement
Acknowledgments
Conflicts of Interest
References
- Long, F.; Yang, H.; Xu, Y.; Hao, H.; Li, P. A strategy for the identification of combinatorial bioactive compounds contributing to the holistic effect of herbal medicines. Sci. Rep. 2015, 5, 12361. [Google Scholar] [CrossRef] [PubMed] [Green Version]
- Ilyasov, I.; Beloborodov, V.; Antonov, D.; Dubrovskaya, A.; Terekhov, R.; Zhevlakova, A.; Saydasheva, A.; Evteev, V.; Selivanova, I. Flavonoids with glutathione antioxidant synergy: Influence of free radicals inflow. Antioxidants 2020, 9, 695. [Google Scholar] [CrossRef] [PubMed]
- Fabre, G.; Bayach, I.; Berk, K.; Paloncýová, M.; Starok, M.; Rossi, C.; Duroux, J.; Otyepka, M.; Trouillas, P. Synergism of antioxidant action of vitamins E, C and quercetin is related to formation of molecular associations in biomembranes. Chem. Commun. 2015, 51, 7713. [Google Scholar] [CrossRef] [PubMed]
- Nikoo, M.; Regenstein, J.M.; Gavlighi, H.A. Antioxidant and antimicrobial activities of (-)-epigallocatechin-3-gallate (EGCG) and its potential to preserve the quality and safety of foods. Compr. Rev. Food Sci. Food Saf. 2018, 17, 732. [Google Scholar] [CrossRef] [Green Version]
- Nogala-Kałucka, M.; Dwiecki, K.; Siger, A.; Górnaś, P.; Polewski, K.; Ciosek, S. Antioxidant synergism and antagonism between tocotrienols, quercetin and rutin in model system. Acta Aliment. 2013, 42, 360. [Google Scholar] [CrossRef]
- Rinaldi, R.; Jastrzebski, R.; Clough, M.T.; Ralph, J.; Kennema, M.; Bruijnincx, P.C.A.; Weckhuysen, B.M. Paving the way for lignin valorisation: Recent advances in bioengineering, biorefining and catalysis. Angew. Chem. 2016, 55, 8164. [Google Scholar] [CrossRef] [Green Version]
- Vinardell, M.P.; Mitjans, M. Lignins and their derivatives with beneficial effects on human health. Int. J. Mol. Sci. 2017, 18, 1219. [Google Scholar] [CrossRef] [Green Version]
- Österberg, M.; Sipponen, M.H.; Mattos, B.D.; Rojas, O.J. Spherical lignin particles: A review on their sustainability and applications. Green Chem. 2020, 22, 2712. [Google Scholar] [CrossRef] [Green Version]
- Alzagameem, A.; Klein, S.E.; Bergs, M.; Do, X.T.; Korte, I.; Dohlen, S.; Hüwe, C.; Kreyenschmidt, J.; Kamm, B.; Larkins, M.; et al. Antimicrobial activity of lignin and lignin-derived cellulose and chitosan composites against selected pathogenic and spoilage microorganisms. Polymers 2019, 11, 670. [Google Scholar] [CrossRef] [Green Version]
- Tran, N.T.; Nguyen, T.T.T.; Ha, D.; Nguyen, T.H.; Nguyen, N.N.; Baek, K.; Nguyen, N.T.; Tran, C.K.; Tran, T.T.V.; Le, H.V.; et al. Highly functional materials based on nano-lignin, lignin, and lignin/silica hybrid capped silver nanoparticles with antibacterial activities. Biomacromolecules 2021, 22, 5327–5338. [Google Scholar] [CrossRef]
- Liu, D.; Li, Y.; Qian, Y.; Xiao, Y.; Du, S.; Qiu, X. Synergistic Antioxidant Performance of Lignin and Quercetin Mixtures. ACS Sustain. Chem. Eng. 2017, 5, 8424. [Google Scholar] [CrossRef]
- Zhang, Y.; Jiang, M.; Zhang, Y.; Cao, Q.; Wang, X.; Han, Y.; Sun, G.; Li, Y.; Zhou, J. Novel lignin-chitosan-PVA composite hydrogel for wound dressing. Mater. Sci. Eng. C Mater. Biol. Appl. 2019, 104, 110002. [Google Scholar] [CrossRef] [PubMed]
- Vijayakumar, R.; Sivaraman, Y.; Siddappa, K.M.P.; Dandu, J.P.R. Synthesis of lignin nanoparticles employing acid precipitation method and its application to enhance the mechanical, UV-barrier and antioxidant properties of chitosan films. Int. J. Polym. Anal. Charact. 2022, 27, 99. [Google Scholar] [CrossRef]
- Yaneva, Z.; Ivanova, D.; Nikolova, N.; Tzanova, M. The 21st century revival of chitosan in service to bio-organic chemistry. Biotechnol. Biotechnol. Equip. 2020, 34, 221. [Google Scholar] [CrossRef]
- Yaneva, Z.; Ivanova, D. Catechin hydrate desorption from newly-synthesized catechin-loaded biopolymer particles. RAD Conf. Proc. 2020, 4, 101. [Google Scholar] [CrossRef]
- Ivanova, D.G.; Yaneva, Z.L. Antioxidant properties and redox-modulating activity of chitosan and its derivatives: Biomaterials with application in cancer therapy. BioRes. Open Access 2020, 9, 64. [Google Scholar] [CrossRef] [Green Version]
- Abudula, T.; Colombani, T.; Alade, T.; Bencherif, S.A.; Memić, A. Injectable lignin-co-gelatin cryogels with antioxidant and antibacterial properties for biomedical applications. Biomacromolecules 2021, 22, 4110. [Google Scholar] [CrossRef]
- Poolman, J.T.; Anderson, A.S. Escherichia coli and Staphylococcus aureus: Leading bacterial pathogens of healthcare associated infections and bacteremia in older-age populations. Expert Rev. Vaccines 2018, 17, 607. [Google Scholar] [CrossRef]
- Álvarez-Martínez, F.J.; Barrajón-Catalán, E.; Encinar, J.A.; Rodríguez-Díaz, J.C.; Micol, V. Antimicrobial capacity of plant polyphenols against Gram-positive bacteria: A comprehensive review. Curr. Med. Chem. 2020, 27, 2576. [Google Scholar] [CrossRef]
- Fu, X.; Shen, Y.; Jiang, X.; Huang, D.; Yan, Y. Chitosan derivatives with dual-antibacterial functional groups for antimicrobial finishing of cotton fabrics. Carbohydr. Polym. 2011, 85, 221. [Google Scholar] [CrossRef]
- Li, X.F.; Feng, X.G.; Yang, S.; Fu, G.G.; Wang, T.P.; Su, Z.X. Chitosan kills Escherichia coli through damage to be of cell membrane mechanism. Carbohydr. Polym. 2010, 79, 493. [Google Scholar] [CrossRef]
- Matica, M.A.; Aachmann, F.L.; Tøndervik, A.; Sletta, H.; Ostafe, V. Chitosan as a wound dressing starting material: Antimicrobial properties and mode of action. Int. J. Mol. Sci. 2019, 20, 5889. [Google Scholar] [CrossRef] [PubMed] [Green Version]
- Lobo, F.C.M.; Franco, A.R.; Fernandes, E.M.; Reis, R.L. An overview of the antimicrobial properties of lignocellulosic materials. Molecules 2021, 26, 1749. [Google Scholar] [CrossRef] [PubMed]
- Yun, J.; Wei, L.; Li, W.; Gong, D.; Qin, H.; Feng, X.; Li, G.; Ling, Z.; Wang, P.; Yin, B. Isolating high antimicrobial ability lignin from bamboo kraft lignin by organosolv fractionation. Front. Bioeng. Biotechnol. 2021, 9, 683796. [Google Scholar] [CrossRef]
- Lund, P.A.; De Biase, D.; Liran, O.; Scheler, O.; Mira, N.P.; Cetecioglu, Z.; Fernández, E.N.; Bover-Cid, S.; Hall, R.; Sauer, M.; et al. Understanding how microorganisms respond to acid pH is central to their control and successful exploitation. Front. Microbiol. 2020, 11, 556140. [Google Scholar] [CrossRef]
- Ning, H.; Li, Y.; Tian, Q.; Wang, Z.; Mo, H. The apoptosis of Staphylococcus aureus induced by glycinin basic peptide through ROS oxidative stress response. LWT 2019, 99, 62. [Google Scholar] [CrossRef]
- Hoyo, J.; Ivanova, K.; Torrent-Burgues, J.; Tzanov, T. Interaction of silver-lignin nanoparticles with mammalian mimetic membranes. Front. Bioeng. Biotechnol. 2020, 8, 439. [Google Scholar] [CrossRef]
- Jangida, A.K.; Poojab, D.; Kulhari, H. Determination of solubility, stability and degradation kinetics of morin hydrate in physiological solutions. RSC Adv. 2018, 8, 28836. [Google Scholar] [CrossRef] [Green Version]
- Marković, Z.; Milenković, D.; Dorović, J.; Dimitrić Marković, J.M.; Stepanić, V.; Lučić, B.; Amić, D. Free radical scavenging activity of morin 2’-O(-) phenoxide anion. Food Chem. 2012, 135, 2070. [Google Scholar] [CrossRef]
- Shinde, S.; Folliero, V.; Chianese, A.; Zannella, C.; De Filippis, A.; Rosati, L.; Prisco, M.; Falanga, A.; Mali, A.; Galdiero, M.; et al. Synthesis of chitosan-coated silver nanoparticle bioconjugates and their antimicrobial activity against multidrug-resistant bacteria. Appl. Sci. 2021, 11, 9340. [Google Scholar] [CrossRef]
- Wang, M.; Li, Z.; Zhang, Y.; Li, Y.; Li, N.; Huang, D.; Xu, B. Interaction with teichoic acids contributes to highly effective antibacterial activity of graphene oxide on Gram-positive bacteria. J. Hazard. Mater. 2021, 412, 125333. [Google Scholar] [CrossRef] [PubMed]
- Bretado-Aragón, L.A.; Jiménez-Mejía, R.; López-Meza, J.E.; Loeza-Lara, P.D. Composites of silver-chitosan nanoparticles: A potential source for new antimicrobial therapies. Rev. Mex. Cienc. Farm. 2016, 47, 7. [Google Scholar]
- Berstis, L.; Elder, T.; Dixon, R.; Crowley, M.; Beckham, G.T. Coupling of flavonoid initiation sites with monolignols studied by density functional theory. ACS Sustain. Chem. Eng. 2021, 9, 1518. [Google Scholar] [CrossRef]
- Nair, V.; Panigrahy, A.; Vinu, R. Development of novel chitosan–lignin composites for adsorption of dyes and metal ions from wastewater. Chem. Eng. J. 2014, 254, 491. [Google Scholar] [CrossRef]
- Lizundia, E.; Sipponen, M.H.; Greca, L.G.; Balakshin, M.; Tardy, B.L.; Rojas, O.J.; Puglia, D. Multifunctional lignin-based nanocomposites and nanohybrids. Green Chem. 2021, 23, 6698. [Google Scholar] [CrossRef] [PubMed]
- Gil-Chávez, J.; Gurikov, P.; Hu, X.; Meyer, R.; Reynolds, W.; Smirnova, I. Application of novel and technical lignins in food and pharmaceutical industries: Structure-function relationship and current challenges. Biomass Conv. Bioref. 2021, 11, 2387. [Google Scholar] [CrossRef]
- Yaneva, Z.; Simeonov, E.; Rusenova, N.; Ivanova, D.; Nikolova, G.; Karamalakova, Y.; Chilev, C.; Beev, G. Flavonoids extraction kinetics, antimicrobial activity and radical scavenging potential of Bulgarian woundwort (Solidago virgaurea L.). Separations 2022, 9, 27. [Google Scholar] [CrossRef]
- Kaneria, M.; Baravalia, Y.; Vaghasiya, Y.; Chanda, S. Determination of antibacterial and antioxidant potential of some medicinal plants from Saurashtra region, India. Indian J. Pharm. Sci. 2009, 71, 406. [Google Scholar] [CrossRef] [Green Version]

| System | S. aureus | B. cereus | P. aeruginosa | E. coli |
|---|---|---|---|---|
| Morin (333.33–1000.00 µg/mL) | - | - | - | - |
| Control (morin) | - | - | - | - |
| CH (2 mg/mL) | - | - | - | - |
| CH (3.33 mg/mL) | 7.0 ± 1.87 | - | - | - |
| CH (5 mg/mL) | 15.0 ± 2.16 | - | 12.0 ± 0.80 | - |
| CH (10 mg/mL) | 16.3 ± 1.09 | - | 15.0 ± 1.28 | - |
| Control (CH) | 10.0 ± 0.35 | - | 12.0 ± 1.56 | - |
| LGN (10 mg/mL) | 12.0 ± 0.92 | - | - | - |
| LGN (50 mg/mL) | 13.5 ± 1.5 | - | - | - |
| LGN (66.6 mg/mL) | 14.3 ± 1.67 | - | - | - |
| LGN (100 mg/mL) | 17.8 ± 1.34 | - | - | - |
| Control (LGN) | - | - | - | - |
| CH–morin | 15.5 ± 2.5 | 15.0 ± 2.74 | - | - |
| Control (CH–morin) | - | - | - | - |
| LGN–morin | 18.5 ± 0.5 | 16 ± 0.82 | - | - |
| Control (LGN–morin) | - | - | - | - |
| CH–LGN | 18.5 ± 1.5 | 13.0 ± 1.26 | ||
| CH–LGN–morin | 15.7 ± 1.69 | 14.0 ± 1.05 | 15.0 ± 1.23 | 14.0 ± 0.88 |
| Control (CH–LGN–H2O) | 15.0 ± 1.3 | 10.0 ± 1.00 | - | - |
| Control (gentamicin) | 23.1 ± 1.01 | 21 ± 1.32 | 20.0 ± 0.65 | 23 ± 0.42 |
| System | Composition/Concentration |
|---|---|
| Single-component systems | |
| Morin (in EtOH:PBS (pH = 4.6) = 1:1) Negative control | 333.30; 500.00; 700.00; 1000.00 µg/mL EtOH:PBS (pH = 4.6) = 1:1, v/v |
| CH (in 1% LA) Negative control | 2.00; 3.33; 5.00; 10.00 mg/mL 1% LA |
| LGN (in distilled water) Negative control | 10.00; 50.00; 66.66; 100.00 mg/mL Distilled water |
| Two-component systems | |
| CH–morin Negative control | CH (10.00 mg/mL):morin (1000.00 µg/mL) = 1:1, v/v LA:EtOH:PBS (pH = 4.6) = 1:0.5:0.5 v/v/v |
| LGN–morin Negative control | LGN (200.00 mg/mL):morin (1000.00 µg/mL) = 1:1, v/v H2O:EtOH:PBS (pH = 4.6) = 1:0.5:0.5, v/v/v |
| CH–LGN | CH (10.00 mg/mL):LGN (200.00 mg/mL) = 1:1, v/v |
| Three-component system | |
| Morin–CH–LGN Negative control | Morin (1000.00 µg/mL):CH (10.00 mg/mL):LGN (200.00 mg/mL) = 1:1:1, v/v/v CH (10.00 mg/mL):LGN (200.00 mg/mL):H2O = 1:1:1, v/v/v |
Publisher’s Note: MDPI stays neutral with regard to jurisdictional claims in published maps and institutional affiliations. |
© 2022 by the authors. Licensee MDPI, Basel, Switzerland. This article is an open access article distributed under the terms and conditions of the Creative Commons Attribution (CC BY) license (https://creativecommons.org/licenses/by/4.0/).
Share and Cite
Yaneva, Z.; Beev, G.; Rusenova, N.; Ivanova, D.; Tzanova, M.; Stoeva, D.; Toneva, M. Antimicrobial Potential of Conjugated Lignin/Morin/Chitosan Combinations as a Function of System Complexity. Antibiotics 2022, 11, 650. https://doi.org/10.3390/antibiotics11050650
Yaneva Z, Beev G, Rusenova N, Ivanova D, Tzanova M, Stoeva D, Toneva M. Antimicrobial Potential of Conjugated Lignin/Morin/Chitosan Combinations as a Function of System Complexity. Antibiotics. 2022; 11(5):650. https://doi.org/10.3390/antibiotics11050650
Chicago/Turabian StyleYaneva, Zvezdelina, Georgi Beev, Nikolina Rusenova, Donika Ivanova, Milena Tzanova, Daniela Stoeva, and Monika Toneva. 2022. "Antimicrobial Potential of Conjugated Lignin/Morin/Chitosan Combinations as a Function of System Complexity" Antibiotics 11, no. 5: 650. https://doi.org/10.3390/antibiotics11050650
APA StyleYaneva, Z., Beev, G., Rusenova, N., Ivanova, D., Tzanova, M., Stoeva, D., & Toneva, M. (2022). Antimicrobial Potential of Conjugated Lignin/Morin/Chitosan Combinations as a Function of System Complexity. Antibiotics, 11(5), 650. https://doi.org/10.3390/antibiotics11050650

